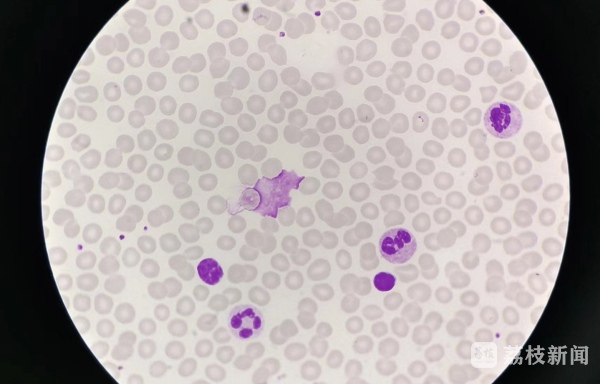

70岁的邢先生退休后每天的生活清闲却充实,晨练、遛狗、接送孙女,忙得不亦乐乎,他平素体质良好,基本上没有吃过一片药丸,近日,在没有任何征兆情况下,他在定期体检中,被确诊为“慢性淋巴细胞白血病”。
在我国,“慢性淋巴细胞白血病”发病率约为0.54/10万,随着人口老龄化趋势的加重以及我国对该病认识和诊断水平的提高,检出率呈明显上升趋势。 然而,由于国内目前对CLL早期认识及诊断率不高,23%的中国慢淋患者曾被误诊为非淋巴瘤,34%的CLL患者需经过多家医院才得以确诊,导致多数患者就诊时已经发展至疾病相对晚期,直接影响疾病进展。加之慢淋好发于老年群体,而这类人通常合并高血压、冠心病等慢性疾病,极大影响了治疗的耐受性以及方案选择,预后情况远低于预期。此外,有不少患者因为出于对疾病的恐惧,他们不信任“观察与等待”等治疗方式,容易导致误诊、过度治疗等现象,影响疾病后续治疗。

今天(9月1日)下午,由北京新阳光慈善基金会发起、中国慢性淋巴细胞白血病工作组(cwCLL)指导、淋巴瘤之家协办、阿斯利康中国公益支持的“中国慢淋日”成立仪式暨“常知久安”国内首个慢淋患者关爱平台发布仪式在南京成功举行。江苏省人民医院血液科主任、中国慢性淋巴细胞白血病工作组组长李建勇教授,哈尔滨血液病肿瘤研究所所长马军教授,中国医学科学院血液病医院淋巴瘤诊疗中心、中国慢性淋巴细胞白血病工作组组长邱录贵教授,江苏省人民医院血液科副主任徐卫教授,北京新阳光慈善基金会秘书长刘正琛先生和淋巴瘤之家创始人顾洪飞先生莅临成立仪式,共同见证了这一里程碑时刻,并围绕慢性淋巴细胞性白血病在中国的诊疗现状、患者未尽之需等话题展开热烈讨论,探讨助力慢淋长期规范治疗的未来发力点。

江苏省人民医院血液科主任、中国慢性淋巴细胞白血病工作组组长李建勇教授
为了加强对临床医生和患者的双重教育、为慢淋患者谋福祉,2017年11月,“中国慢性淋巴细胞白血病工作组(cwCLL)”在李建勇教授及邱录贵教授的带领下应运而生,旨在推动慢淋诊疗规范化建设,提升中国医生的学术和诊疗水平。谈到此,李建勇教授表示:“中国慢淋工作组自成立以来,大多省市、自治区成立了慢淋工作组,不断普及‘全国慢淋中心‘建设工作,成立中国慢淋示范中心、卓越中心和规范中心,整体提升我国慢淋诊治水平。此外,近年来随着BTK抑制剂的出现,慢淋已经进入了长生存时代,这对于医患双方也提出了更高的要求和需要更密切的配合,除了医生以外,患者也应更加主动、科学地了解和评估自身健康情况,确保院外也能进行规范化疾病管理。”
靶向治疗开启无化疗时代,慢淋治疗目标是尽可能延长生存时间,改善生活质量
会上,在谈到中国慢淋诊疗现状时,邱录贵教授指出:“对于慢淋患者来说,一经确诊应当进行全面评估与病情分层,我们发现中国慢淋患者中携带无del(17p13) 的TP53突变的频率较高于其它国家,对于这类患者化疗为基础治疗模式不能克服和改善预后,需要耐受性和安全性更好的靶向治疗方式。我们鼓励患者根据医生的指引规范治疗,这是延缓疾病进展、延长生存时间的重要途径。”
徐卫教授表示:“BTK抑制剂的出现使慢淋患者生存期进一步延长,成为像高血压、糖尿病一样长期治疗的慢性疾病。一方面,所有患者应终身观察和随访,定期随访可以提高生活质量。另一方面,很多老年慢淋患者无法耐受化疗,靶向BTK抑制剂是更适合的一种治疗选择。但是许多患者和家属担心感染、出血、房颤等不良反应,期待未来的创新药物能满足这一群体的未尽之需。”
慢淋关爱从全球来到中国,各方携手聆听患者真实诉求,助力提升患者生存获益
2021年9月1日,国际慢淋倡导组织(CLLAN,CLL ADVOCATES NETWORK)建立了“世界慢淋日“,希望全球慢淋社区都能联合起来,提高社会对慢淋的关注。“中国慢淋日“的设立,不仅是响应CLLAN的号召,让世界血液肿瘤领域听到中国的声音,其意义在于提高社会公众对慢淋这一不常见的老年血液肿瘤的认知,呼吁全社会给予慢淋患者更多的关爱和理解,同时鼓励患者积极规范化治疗、慢步人生路。
为此,北京新阳光慈善基金会的秘书长刘正琛先生表示:“作为以老年人为主的“沉默”群体,慢淋患者的心声时常被淹没在人群中。我们希望借助社会各界的力量帮助公众进一步了解慢淋患者的治疗现状与生存状况,呼吁社会关注慢淋以及慢淋患者群体,让更多患者获益于规范化的诊疗和长期疾病管理,收获身心健康,迈向康享人生。”协办方淋巴瘤之家创始人顾洪飞先生补充道:“慢淋患者由于对慢淋疾病情况和治疗理念的认知度较低,使得他们的战胜疾病信心和疾病管理能力受到很大影响,导致延误必要的治疗手段,甚至危及生命。我们一方面全力鼓励慢淋患者以更加积极的心态配合治疗,另一方面也呼吁社会关注脆弱的患者群体,为他们在与疾病抗争路途中的患者送上支持和力量。”
今日,慢淋关爱平台 “常知久安”微信小程序便是该理念的最佳实践,借助数字化力量,打造出一个专属于患者、且易于他们获取疾病知识和力量的移动守护平台。通过每日更新慢淋疾病知识,帮助慢淋患者在院外获取专业有用的疾病信息,而社会公众可通过每日捐步给予慢淋患者一份鼓励和支持,携手多方力量助力慢淋患者在与疾病的抗争中少走弯路,常知久安,健康可期。
在我国医疗卫生高质量发展和推动《“十四五”健康老龄化规划》实施的关键时期,如何提升公众慢淋疾病认知、普及慢淋规范化治疗与长期管理理念成为摆在眼前的重要课题。在各方力量的共同守护之下,”中国慢淋日”与“常知久安”慢淋关爱平台将成为一扇窗、一座桥、一股力,持续为慢淋患者浇筑一条健康可期、通往美好晚年生活的康健大道。
(来源:江苏广电融媒体新闻中心/方晨 编辑/汪泽)







公安备案号:32010202010067